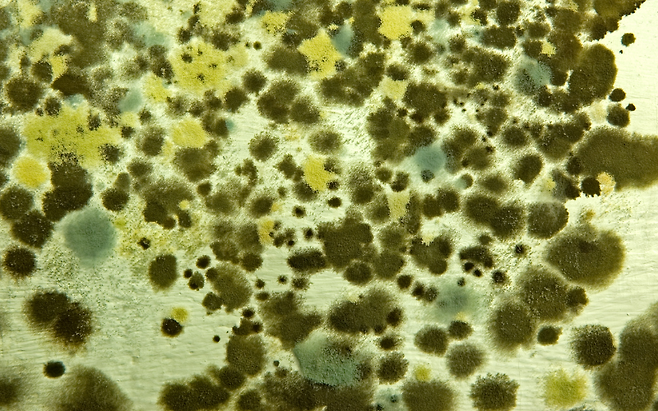

매일 쓰는 행주, 얼마나 자주 삶아 쓰고 계신가요? 겉보기에 깨끗해 보여도 그 안에는 수천 마리의 세균이 숨어 있을 수 있습니다.
특히 행주에서 나는 특유의 쉰 냄새가 난다면 이미 경고 신호입니다. 그 냄새 속엔 건강을 위협하는 위험한 균들이 번식 중일 수 있습니다.
행주는 ‘세균 온상’입니다

젖은 행주는 따뜻한 실내 공기 속에서 습기를 머금은 채 방치되기 쉽습니다. 이 상태에서 식중독균인 황색포도상구균, 대장균, 살모넬라균 등이 급속도로 증식할 수 있습니다.
특히 식탁, 조리도구를 닦을 때 사용한 행주를 제대로 세척하지 않으면 세균이 음식으로 옮겨가고, 이를 섭취한 가족에게 감염성 위장염이나 호흡기 질환을 일으킬 수 있습니다.
쉰 냄새는 이미 ‘부패’된 신호입니다
행주에서 나는 냄새는 세균과 곰팡이로 인한 휘발성 유기화합물 때문입니다.
이 냄새를 맡는다는 건 이미 오염된 공기를 흡입하고 있다는 뜻이며, 특히 면역력이 약한 아이나 노인에게는 폐렴균 감염 가능성도 높아집니다. 가정에서 사용하는 행주라고 해서 안전하다는 보장은 없습니다.
‘삶기’와 ‘완전 건조’가 가장 중요합니다

행주는 최소 주 2회 이상 삶아 사용하는 것이 권장됩니다. 삶은 후에는 햇빛에 바짝 말리거나 전자레인지에 1분 이상 가열해 완전 건조시켜야 합니다.
그렇지 않으면 다시 젖은 채로 방치돼 세균이 다시 증식하게 됩니다. 가능하다면 일회용 키친타월을 사용하는 것도 위생 관리에 효과적입니다.

숨을 들이쉬는 순간, 당신도 모르게 세균을 들이마시고 있을 수 있습니다. 매일 입에 닿는 음식은 결국 이 행주를 거쳐갑니다. 냄새로 먼저 확인하고, 평소보다 더 꼼꼼히 행주 위생을 챙겨야 할 때입니다.
Copyright © 뇌생각